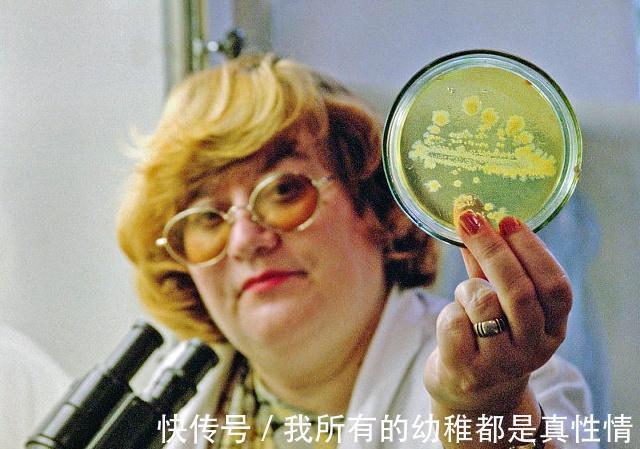
乳腺癌|抗癌44年的她，如今93岁，总结出的4条经验，可能深有体会

乳腺癌|抗癌44年的她,如今93岁,总结出的4条经验,可能深有体会
说起癌症,很多人都感到特别恐慌,查出癌症后,不仅个人的精神受到了崩溃而且也给家里造成了沉重的打击和负担。有的人一旦得了癌症就会打不起精神,反而使疾病越来越严重,但是有的人却恰恰相反,他们为了自己的身体,坚强的与疾病作斗争,如今93岁的刘松寒与癌症抗争已经有44年的时间了,很多人都亲切的称她为“抗癌斗士”,在1975年的时候,49岁的刘沧海查出患有乳腺癌,在半年之后又由于子宫出血做了全切手术,在这40年间,癌细胞也反复发作并且转移了三次,医院都为他下达了病危通知书,但是她仍然和病魔做斗争,仍然在抗癌的路上奋斗着。

文章插图
抗癌44年的她,如今93岁,总结的4条经验,可能深有体会1、拥有坚强意志癌症是一种可怕的疾病,北京肿瘤医院的院长就曾经说过,癌症有1/3是可以治好的,有1/3是不能够被治好的,还有1/3是被自己吓死了,虽然这句话说起来比较的值班,但是我们可以从这句话当中我看出了心态的重要性,人的情绪是靠事情而进行改变的,有的人在没查出癌症之前活蹦乱跳,一旦确诊癌症就会变得杞人忧天,只有调整好心态,有坚强的意志才能够积极配合医生的治疗,刘松寒就是具有了坚强的意志,她一直在为自己的身体谋福利,一次一次的闯过难关,这样才遏制住细胞进行改变。
文章插图
2、科学治疗刘松寒在1975年查出乳腺癌后,半年之后又把子宫切除了,后来因为癌细胞扩散到肺部,她又切除了一根肋骨和右下肺,后来的三个月时间,癌细胞又进行了转移,但是他仍然没有放弃,希望通过一次一次的科学治疗,最后闯过了难关,对待癌症这件事,科学的治疗方法是非常重要的,所以大家在发现疾病的时候不要慌张,一定要根据医生的治疗方法,进行科学的治疗。

文章插图
3、合理的饮食当发现癌症的时候,很多人觉着自己的生命已经快结束了,也没有必要进行抗争,就想着生命在结束之前能够尽情的享受生活,但是刘松寒并不是这样的,他在得知自己患乳腺癌之后,不仅没有丧失和癌症斗争的决心,在饮食上也特别注意坚持少油少盐的饮食,多吃蔬菜和五谷杂粮,而且从来不吃油炸食物,饮食上的调整对于治疗疾病有着重要的作用,所以在患有疾病的时候,一定要保持合理的饮食,这样才能够给身体补充营养。

文章插图
4、坚持锻炼锻炼有效的增强我们的体质,而且还能够使身心做好调整,他能够与癌症做斗争,坚持锻炼有效的加强人体的抵抗力和免疫力。在锻炼的时候,也应该听从医生的叮嘱,锻炼起到辅助治疗的效果,能够使精神更加的充实,而且也会有更多的信心应付癌症。当癌症来临的时候,我们就应该保持一个积极的心态,千万不要被病魔打败,就像刘松寒女士这样坚强的与病魔做抗争,能够有效的帮助自己的身体谋取福利。希望这一个案例能够给你的生活带来更大的鼓舞,感谢您的阅读和推荐。
- 免疫|1碗抗癌汤消炎、抗氧化、强免疫!利用大白菜、菇类快速搞定
- 肿瘤|健康大讲堂丨肿瘤专家袁芃:乳腺癌病因尚不明确 防治重在“三早”
- 西红柿排毒美肤 你想不到的抗癌美食西红柿
- 风险|临床医生说科普丨如何区别乳腺增生和乳腺癌
- 美味西兰花 抗癌小帮手
- 西兰花的营养价值和抗癌功效
- 免疫|乳腺癌患者必看!这些常用药要慎服丨“乳”此治疗
- 抗癌|一位75岁老人感慨,宁可早日离去,也不愿活得长寿,原因有这三点
- 带着孩子往老家奔|一家人齐动手,一大桌菜半小时搞定,年的感觉有啦
- 螃蟹美味又营养 为您推荐螃蟹吃法
